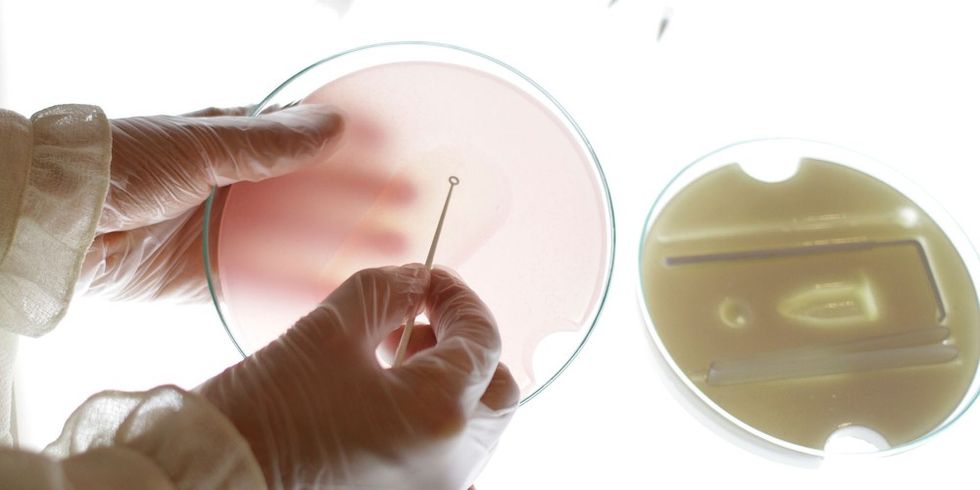
GutBacteria N1611 ts508697480

Viruset nuk na sulmojnë! (Viruset vetëm bartin informata!)

Nëse trupi nuk pastrohet mjaftueshëm, nuk djersitet, nuk pastrohen zorrët rregullisht, nuk urinon rregullisht, ose vjen deri tek (in)toksikimi përmes ajrit, ujit, ushqimit ose rrezatimit, atëherë mund të vijë deri te prishja e qelizës, nga e cila lëshohet material gjenetik ADN dhe ARN, i mbështjellur me një membranë, pra kjo strukturë e tillë quhet "virus"
Pra, ato që ne i quajmë viruse janë pjesë proteinike të materialit gjenetik të dekompozuara të një qelize të (in)toksikuar, të shkatërruar. Viruset nuk janë qenie të gjalla dhe nuk shumohen.
Nëse dikush është helmuar nga ndonjë toksinë e caktuar, material gjenetik, thënë thjeshtë, nga ndonjë "virus", nuk do ta transmetojë atë toksinë te dikush tjetër, por informacionin me të cilin ai trup është (in)toksikuar dhe sinjalin se duhet të aktivizohen mekanizmat e pastrimit. Trupi pastrohet me anë të temperaturës, vjelljes, jashtëqitjes së lëngshme, puçrrave — të cilat mjekësia korporative i konsideron si "sëmundje", por e vërteta është se ato janë reaksione të detoksifikimit.
Pra, viruset janë mesazhe, informata, që përhapen nëpër trup e që paralajmërojnë për toksinat e shkaktuara në të.
Informatat apo viruset mund të barten (transmetohen) në trupa tjerë, dhe nëse trupi tjetër ka toksina të caktuara në vetvete, do të paraqitet temperaturë - që i djeg toksinat, do të paraqiten puçrra dhe mekanizma tjerë pastrues. Nëse nuk ka toksina, nuk do të ketë detoksifikim. Kjo është arsyeja pse disa njerëz sëmuren, disa nuk sëmuren dhe disa të tjerë kanë simptoma të lehta për 1-2 ditë.
Prandaj, viruset nuk janë në "luftë" me neve, nuk na sulmojnë neve, ato nuk bartin (transmetojnë) toksina, por ato bartin (transmetojnë) informata.
Lind pyetja, atëherë si reagon trupi, përderisa nuk ka toksina e nuk ka mikrobe të këqija që na sulmojnë?! Imagjinojeni kur dikush na tregon ndonjë lajm të keq! Ne do të reagojmë sikur të (na) ndodhte vërtetë (neve), trupi ynë do të tajojë hormone të stresit, dikush madje mund edhe të bjerë për vdekje. Pra, ne vetëm kemi marrë lajm (informata) për një ndodhi që ne nuk e kemi parë (përjetuar).
Përse këto grimca proteinike përhapen nëpër trup, dhe ndonjëherë nga trupi në trup?! Ngase ato na paralajmërojnë neve për rreziqe (sëmundje), për toksinat (helmet) e shkaktuara. E gjitha ka të bëjë me simbiozën (bashkëjetesën) në natyrë. Askush nuk sulmon askënd, çdo gjë i ndihmon dikujt a diçkaje.
Imuniteti nuk formohet në bazë të viruseve, por viruset janë si pasojë e imunitetit — viruset janë rezultat i reagimit imunitar të trupit ndaj toksinave, vaksinave, rrezatimit, ushqimit të keq, ushqimit të modifikuar gjenetikisht (OMGj), etj.
Bakteret janë qenie të gjalla; ato shkatërrojnë toksinat, prodhojnë vitamina bazike dhe faktorë imunë, ndërsa kërpudhat (fungi, mikroorganizmat) shpërbëjnë qelizat e vdekura. Këto janë ndihmuesit tanë, pastruesit tanë, pa të cilët organizmi nuk do të ishte në gjendje të funksiononte. Nëse, për shembull, biem në kontakt me një bakter, në një trup të shëndetshëm, bazik, bakteri do të kthehet në një formë më pak patogjene. Nëse trupi është i kontaminuar (ndotur), bakteri do të vazhdojë të shumohet dhe produktet e metabolizmit të bakterit do të çojnë në simptoma të "sëmundjes", siç tregon Dr. Robert Young.
Derisa njerëzit janë vazhdimisht në kontakt me të gjitha llojet e patogjenëve, ndonjëherë testet mund të tregojnë praninë e tyre, por kjo është jetëshkurtër, një ditë, dy, tre, derisa mikroorganizmi të shndërrohet në një formë më pak patogjene. Prandaj, është e mundur që ndonjëherë ka patogjenë dhe nuk ka simptoma të sëmundjes.
Forma patogjene e mikrobeve nuk mund të ruhet aty ku nuk ka kushte patogjene për mbijetesën e saj. Ashtu si mushkonjat nuk mund të shumohen aty ku nuk ka kënetë.
Sipas Prof. Antoine Béchamp, Prof. Dr. Günther Enderlein dhe shumë shkencëtarë të tjerë, mikrobet kanë ciklin e tyre pleomorf, që do të thotë ato kalojnë nga forma bazë somatide, së pari në forma beninje dhe më pas në forma patogjene, në varësi të zvogëlimit të pH-së domethënë aciditetit dhe kontaminimit të trupit. Në një mjedis shumë acidik, vjen deri te shndërrimi në kërpudha (fungi, mikroorganizma), produktet metabolike të të cilave janë jashtëzakonisht toksike (siç është rasti me kancerin dhe disa çrregullime të tjera).
Format patogjene të mikrobeve, për shkak të produkteve shumë toksike të metabolizmit të tyre, mbeturinave që ato nxjerrin, mund të (in)toksikojnë organizmin dhe të shkaktojnë pastrim shumë të vështirë, gjë që është e vështirë për ta duruar, dikush me një organizëm të dobësuar.
Kur merrni antibiotikë, ka një përmirësim, sepse antibiotiku, anti-bios = kundër jetës, ka shkatërruar disa baktere, kështu që edhe sasia e mbeturinave që ato hedhin do të jetë më e vogël. Sigurisht, kjo nuk e zgjidh problemin, por numri i patogjenëve zvogëlohet dhe në atë mënyrë organizmi zgjat funksionimin e tij edhe për disa kohë. Gjatë shpërbërjes, mikroorganizmat do të lënë sasi të mëdha mbetjesh, të cilat gjithashtu do të rëndojnë organizmin.
Pra, bakteret nuk janë problematike, por produktet e metabolizmit të tyre, domethënë mbeturinat e tyre. Derisa numri i baktereve është i paktë, ato nuk do të na shkaktojnë ndonjë problem, por nëse trupi është i (in)toksikuar dhe acidik, ato do të shumohen, kështu që sasia e mbetjeve që ato heqin do të rritet dhe trupi ynë do të reagojë duke u pastruar.
Bakteret nëpërmjet sekrecioneve mund të vendosen në një trup tjetër, por ato shpejtë do të humbasin formën e tyre patogjene nëse nuk ka aciditet të caktuar në trup. Pra, nuk mund të qëndrojnë në një trup të shëndetshëm, ndërsa në një trup të sëmurë mund të vazhdojnë riprodhimin e tyre dhe produktet e metabolizmit të tyre mund të çojnë në simptomat e "sëmundjes".
Çka duhet kuptuar është se simptomat nuk janë sëmundje por përpjekja e trupit për t’u shëruar.
Ashtu sikurse mushkonjat pastrojnë moçalin dhe mikrobet shpërbëjnë lëndën e vdekur në plehra, ashtu edhe në trupin tonë, mikrobet shpërbëjnë toksinat dhe mbeturinat. Ashtu si këneta dhe plehrat që nuk kanë infeksion, por pastrohen, ashtu edhe trupi që ka ndonjë bakter ose virus nuk ka infeksion, por pastron vetveten.
Mos harroni, ne nuk jemi në luftë me viruset, bakteret dhe kërpudhat (fungi), por jetojmë në simbiozë, ato janë pastruesit tanë, dhe pa to, rigjenerimi i trupit do të ishte i pamundur. Trupi është i ndotur me toksina nga ajri, kimikate nga uji, ushqime artificiale nga supermarketi, ndërsa mikroorganizmat janë pastrues që pastrojnë vazhdimisht toksinat që fusim në trupin tonë çdo ditë.
Nga zemra, gjaku shkon në mushkëri për t’u pastruar nga toksinat e rrezikshme që ka marrë duke qarkulluar nëpër trup. Megjithatë, kur marrim frymë në ambiente të mbyllura, veçanërisht në dimër, në vend që të nxjerrim toksina dhe të thithim ajër të pastër që do të ushqejë qelizat tona, gjaku ndotet me toksina.
Në këtë rast, ne thithim mbeturina toksike, mu sikur të hamë prapë atë që kemi vjellur. Pas një kohe (në varësi të shkallës së vitalitetit), trupi fillon mekanizmat e pastrimit, temperaturë, puçrra, të vjella, kollë, jashtëqitje të lëngshme, djersitje etj., të cilat mjekësia e sotme i quan 'sëmundje' të shkaktuara nga mikrobet.
Kollitja dhe teshtitja janë procese pastrimi që shpëtojnë jetën, të cilat, nën një presion të madh, dëbojnë papastërtitë dhe gazrat helmuese, të cilat ndotin gjakun. Ne duhet t'i përdorim ato dhe të mos i frenojmë, gjë që bën mjekësia klasike. Në vend të kësaj, ju duhet të largoni shkakun e kollës - ajrin e ndotur.
Nëse frenojmë kollitjen dhe teshtitjen, ajri helmues do të kalojë përmes gjakut në të gjitha pjesët e trupit tonë, gjë që do të çojë në pneumoni dhe sëmundje të tjera të rënda. Nxjerrja e frymës heq sëmundjen nga trupi ynë. Gjithashtu, në dimër, nuk ka diell, nuk ka vitaminë D, nuk ka kontakt me tokën dhe jonet negative, kështu që pastrimi, që mjekësia e sotme e quan 'grip', është shumë i pritshëm në këto kushte.
Le të dalim nga qytetet e mbuluara me batanijen e zymtë dhe të helmuar që na vret dhe na sëmur, le të hapim dritaret dhe të thithim ajër të pastër! Ajri që thithim është shumë më i rëndësishëm sesa ushqimi që hamë.
Dhe mbani mend, viruset, bakteret dhe kërpudhat (fungi, mikroorganizmat) na mbrojnë, ato nuk na sulmojnë.
Dr. Sladjana Velkov(Tekstin e përshtatën: E. Arifi dhe I. Reshiti)